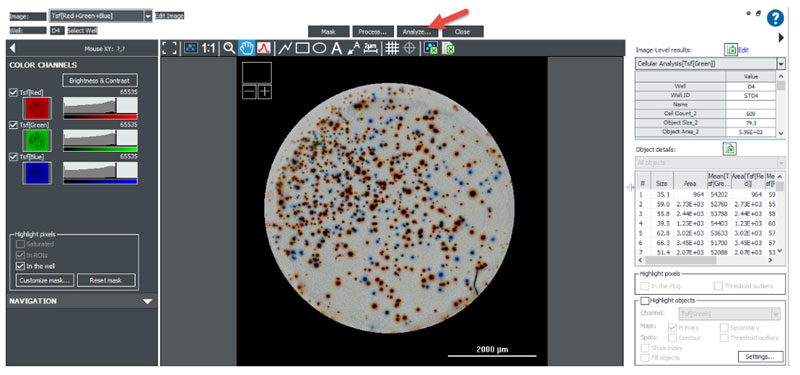

ELISpot
March 2020
The enzyme-linked immunospot (ELISpot) assay is a flexible and sensitive method for investigating the frequency of cytokine-secreting cells within a population. ELISpot is particularly useful for analyzing the immunological functions and responses of peripheral and lymphoid white blood cells, enabling detection of individual cytokine-secreting cells.
The ELISpot assay procedure is very similar to that of a conventional ELISA. Membrane-backed microplates are first coated with the appropriate concentration of capture antibody and allowed to absorb. The unbound antibody is aspirated and the plate is washed. Each well is then filled with a blocking solution and allowed to incubate at room temperature. Alternatively, a variety of ELISpot kits are available with microplates pre-coated with capture antibody and blocked to prevent non-specific protein binding. Cultured secreting cells are added to the prepared microplate wells along with any experimental mitogen or antigen of interest. Cells are maintained for an appropriate incubation period after which they are removed by washing. Secreted molecules remain bound to the capture antibodies in close proximity to the location on the membrane where secreting cells were situated. Enzyme-conjugated detection antibodies and substrate are then added, generating a precipitating product that is visible on the microplate surface.
There are a number of alternative immunoassays available for measuring cytokine secretion in which cytokines can be measured, each with advantages and disadvantages. Enzyme-linked immunosorbent assays (ELISA) are most often used to measure cytokines in serum or plasma, however binding proteins, rapid turnover, and detection difficulties can limit their effectiveness. In situ-hybridization and reverse transcription-PCR can be used to measure cytokine mRNA expression, but these results may or may not reflect true cytokine protein levels. In contrast, ELISpot assays enable sensitive identification of actively secreting cells from a mixed population with limits of detection down to 1 in 100,000 cells.
BioTek provides a full range of automated solutions for conducting ELISpot assays across all commonly used formats. Optimized image acquisition and analysis protocols for the Cytation 7 Cell Imaging Multimode Reader deliver accurate and reproducible results. Additionally, integrating the BioTek 405 TS Washer automates the most labor intensive aspect of the ELISpot workflow, while the BioStack Microplate Stacker enables processing up to 50 plates.
Featured Applications
Stimulation of Human Peripheral Blood Mononuclear Cells

Human Peripheral Blood Mononuclear Cells (PBMCs) are routinely isolated from blood samples and then used in several fields of research including autoimmune disorders, infectious diseases, vaccine development and cancers. The ELISpot assay monitors ex vivo cellular immune responses to antigenic stimuli. Here we use the Cytation 7 Cell Imaging Microplate Reader in conjunction with Gen5 Microplate Reader and Imager Software to quantitate changes in cytokine secretion in PBMCs using the colorimetric ELISpot assay format.
Automating the Wash Steps of ELISpot Assays using BioTek's 405 TS Microplate Washer

Enzyme-linked immunospot (ELISpot) assays are a flexible and powerful tool for investigating secreted molecules from whole cells, particularly for analyzing the immunological functions and responses of peripheral and lymphoid white blood cells. The ELISpot assay can provide information regarding secreted molecules that other techniques cannot. While the analysis of the ELISpot assay can be automated using the Cytation 7 Cell Imaging Multi-Mode Reader, the wash steps inherent in the assay have usually been accomplished manually. Here we describe a convenient and effective method for automating the most tedious aspects of conducting ELISpot assays using the versatile 405 TS Microplate Washer.
Product Spotlight
Cytation 7 Cell Imaging Multi-Mode Reader
Cytation 7 Cell Imaging Multi-Mode Reader combines automated digital upright and inverted widefield microscopy with monochromator-based multi-mode microplate reading. The inverted microscope provides 1.25x to 60x magnification in fluorescence, brightfield and color brightfield, while the upright microscope enables other common applications including ELISpot imaging, slide scanning and ROI detection.

Watch this video to learn more about the complete Cytation line of cell imaging multi-mode readers.
405 TS Washer
The 405 TS Microplate Washer features the patented Verify technology, which runs an automated QC check for manifold tube blockage, and visually reports any failed wells. The patented Ultrasonic Advantage can then be used to automatically and thoroughly clean the aspirate and dispense manifolds. The 405 TS, with the unique Verify and Ultrasonic Advantage features, overcomes the common problem of undetected washer manifold clogging which can lead to assay failure. The 405 TS is the first self-checking, self-maintaining microplate washer available!
Tek Tips
Setting up Automated Wash Parameters for ELISpot Assays
ELISpot wash routines can be run using the MultiFlo FX, ELx50 strip washers or the EL406 and 405 TS full plate washers depending on the throughput needs. The Strip washers have the advantage of being able to run partial plates, while the full plate washers will rapidly wash an entire 96-well microplate. The most commonly used ELISpot PVDF membrane plates are Millipore MSIPS4610 (clear sided) and MSIPS4W10 (white sided) 96-well microplates. Depending on the assay kit, the number of wash cycles used in each wash step varies.
Default aspiration and dispense rates work well for most ELISpot assay formats. To optimize plate positioning, select the “Advanced Options” button to define X, Y, and Z offsets. We have found that aspirating towards one edge of the well provides the best results, thus X position of 48, which moves the aspiration tubes over 2 mm to the right of the center of the well. A slight Y offset to the front accommodates any plate misalignment. Confirm that the Z-axis setting positions the aspiration tube slightly above the membrane without contacting it during the aspiration step.
Refer to the assay kit insert for dispense volumes, but these are generally between 200 and 300 µL per cycle. When all of the parameters have been optimized, save the LHC file under a unique file name and you are reader to wash ELISpot plates.
Image Analysis for 2-Color ELISpot
Recently 2-color ELISpot assays have been developed that detect and quantitate the number of cells secreting two different cytokines. Each cytokine is identified by a specific antibody/conjugate pair that results in the formation of two (red and blue) different colored spots.
To conduct the 2-color ELISpot assay, the prepared PVDF membrane backed plate is color brightfield imaged in the same manner as a standard colorimetric ELISpot assay. After imaging and background subtraction, spots are identified using threshold and size analysis of the Tsf[Green] channel.
Subpopulation Analysis:
Differentiation between red and blue spots is accomplished using subpopulation analysis of the total spot population identified using the Green channel. Once spots are identified, the Gen5 protocol will automatically calculate the mean red and blue intensity values, as well as the red to blue ratio for each object. Subpopulation criteria can be determined empirically or by using red-only and blue-only control wells to define cut off thresholds for their respective spots.

Figure 2. The population mean plus 2-3 standard deviations of a red-only well can be used to define the upper threshold of the ratio for red spots. Likewise, the population mean minus 2-3 standard deviations can be used to define the lower limit of blue spots. Spots with ratio values in between red and blue would be considered a mix of the two colors.

Figure 3. The results of these cut off values can be examined with a frequency histogram of data from wells that have had red and blue colors developed. Having defined Red, Blue and red and blue cut off criteria previously with the scatter plot, Gen5 identifies these subpopulations in the histogram automatically.
Webinar
Advances in Quantitative Image-Based Applications Utilizing a Powerful and Unique Combination of Imaging Tools
Presenter: Paul Held, PhD, Applications Laboratory Manager, BioTek Instruments, Inc.
BioTek's Cytation Cell Imaging Multi-Mode Readers are the most advanced microplate readers on the market, delivering performance, versatility and reliability in a unique, patented design. With the recent release of the Cytation 7 and the available upright microscopy module, we've further expanded the range of supported applications.
In this webinar we will describe workflows and tips for optimizing a range of recently developed assays, emphasizing integrated automation for increased efficiency and accurate quantitative analysis.

For Research Use Only. Not for use in diagnostic procedures.